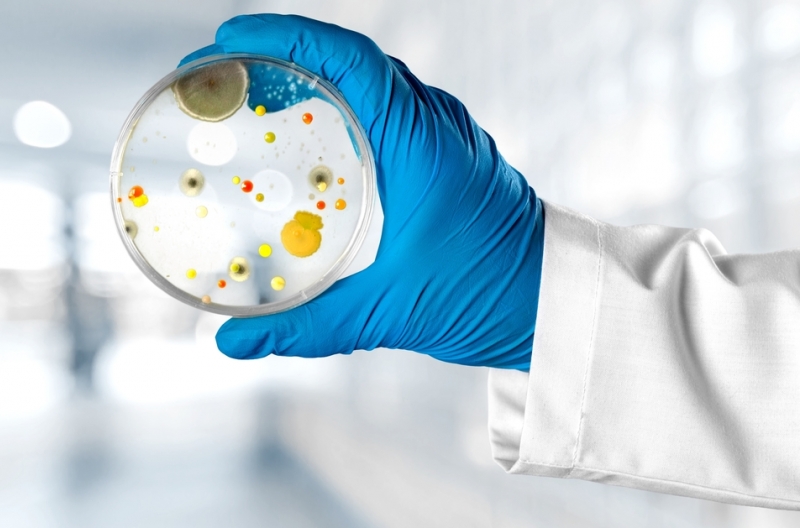

Informations du cours
Practical work (lab sessions) are educational activities conducted in a laboratory setting, aimed at applying the theoretical knowledge acquired in the modules "Analytical Tools", "Microbiology", and "Safety". They enable learners to develop technical skills, carry out scientific protocols, interpret results, and adopt good professional practices.
Lab sessions allow for the observation, cultivation, identification, and quantification of microorganisms. During these sessions, learners apply aseptic techniques, sterilization methods, inoculation procedures, and handling of culture media.- Enseignant: BOUSSAID Maghnia